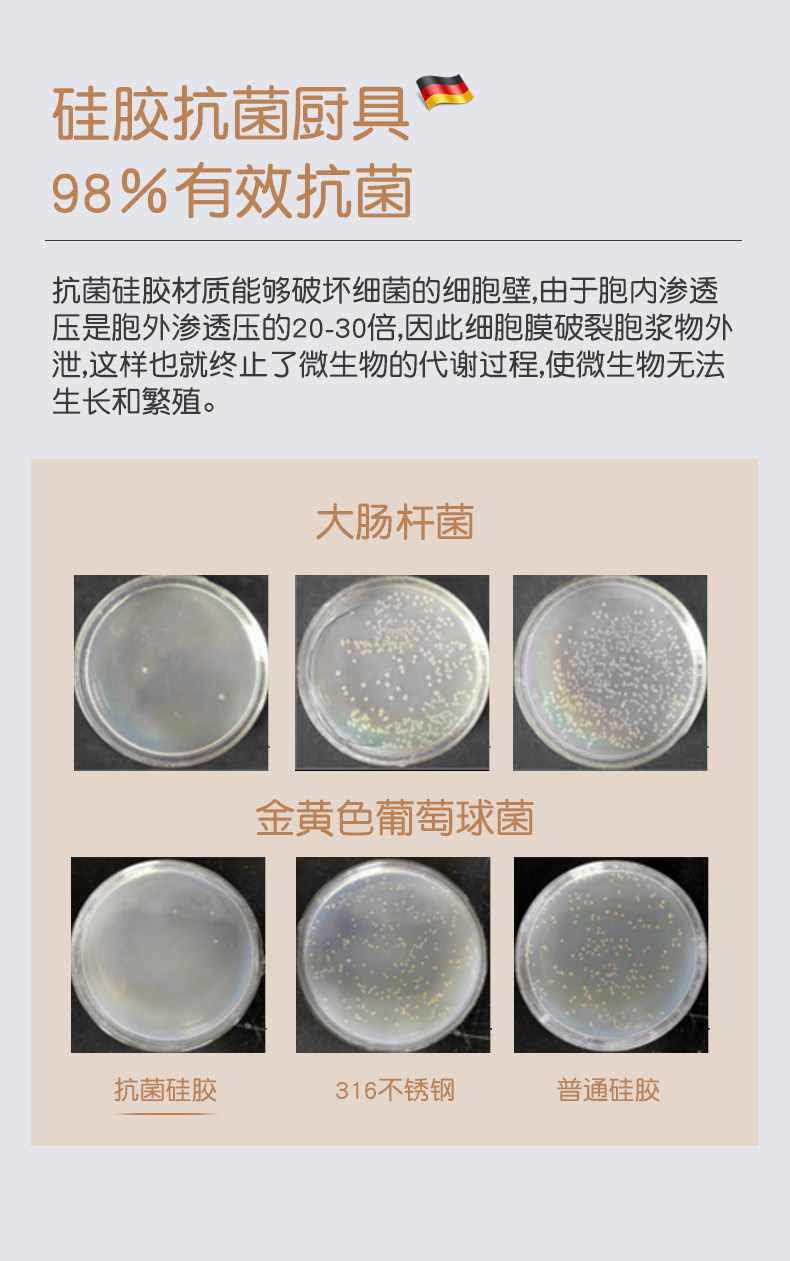

Высококлассная силиконовая лопата, кухонная утварь, комплект

Цена: 24 049-28 235руб. (¥1149)
Артикул: 681162617979
Вес товара: ~0.7 кг. Указан усредненный вес, который может отличаться от фактического. Не включен в цену, оплачивается при получении.
Описание товараPGltZyBzcmM9Imh0dHBzOi8vaW1nLmFsaWNkbi5jb20vaW1nZXh0cmEvaTQvMjIxMTI0MDIyODA3MS9PMUNOMDFrTG1Qa1MyOVVaUTV4akhvdF8hITIyMTEyNDAyMjgwNzEuanBnIj48aW1nIHNyYz0iaHR0cHM6Ly9pbWcuYWxpY2RuLmNvbS9pbWdleHRyYS9pNC8yMjExMjQwMjI4MDcxL08xQ04wMWxFdFNvazI5VVpRRlVwUmJDXyEhMjIxMTI0MDIyODA3MS5qcGciPjxpbWcgc3JjPSJodHRwczovL2ltZy5hbGljZG4uY29tL2ltZ2V4dHJhL2k0LzIyMTEyNDAyMjgwNzEvTzFDTjAxY3U2RVNoMjlVWlFIWnFpT3pfISEyMjExMjQwMjI4MDcxLmpwZyI+PGltZyBzcmM9Imh0dHBzOi8vaW1nLmFsaWNkbi5jb20vaW1nZXh0cmEvaTQvMjIxMTI0MDIyODA3MS9PMUNOMDFTR2preGsyOVVaUUVqNlVnNl8hITIyMTEyNDAyMjgwNzEuanBnIj48aW1nIHNyYz0iaHR0cHM6Ly9pbWcuYWxpY2RuLmNvbS9pbWdleHRyYS9pMS8yMjExMjQwMjI4MDcxL08xQ04wMVZZVFVoRzI5VVpRSFpxMnA3XyEhMjIxMTI0MDIyODA3MS5qcGciPjxpbWcgc3JjPSJodHRwczovL2ltZy5hbGljZG4uY29tL2ltZ2V4dHJhL2k0LzIyMTEyNDAyMjgwNzEvTzFDTjAxeTdCblk2MjlVWlE5Mk11UnBfISEyMjExMjQwMjI4MDcxLmpwZyI+PGltZyBzcmM9Imh0dHBzOi8vaW1nLmFsaWNkbi5jb20vaW1nZXh0cmEvaTIvMjIxMTI0MDIyODA3MS9PMUNOMDFRWDBjcUMyOVVaUURhZzhVS18hITIyMTEyNDAyMjgwNzEuanBnIj48aW1nIHNyYz0iaHR0cHM6Ly9pbWcuYWxpY2RuLmNvbS9pbWdleHRyYS9pMS8yMjExMjQwMjI4MDcxL08xQ04wMUE4T2JNRDI5VVpROTJLUWJFXyEhMjIxMTI0MDIyODA3MS5qcGciPjxpbWcgc3JjPSJodHRwczovL2ltZy5hbGljZG4uY29tL2ltZ2V4dHJhL2kxLzIyMTEyNDAyMjgwNzEvTzFDTjAxUUF1UjhWMjlVWlE4RmJaV0hfISEyMjExMjQwMjI4MDcxLmpwZyI+PGltZyBzcmM9Imh0dHBzOi8vaW1nLmFsaWNkbi5jb20vaW1nZXh0cmEvaTIvMjIxMTI0MDIyODA3MS9PMUNOMDFLN3paeUEyOVVaUTNpOUJpYV8hITIyMTEyNDAyMjgwNzEuanBnIj48aW1nIHNyYz0iaHR0cHM6Ly9pbWcuYWxpY2RuLmNvbS9pbWdleHRyYS9pMS8yMjExMjQwMjI4MDcxL08xQ04wMVRrNDNBUDI5VVpROTJLOXlRXyEhMjIxMTI0MDIyODA3MS5qcGciPjxpbWcgc3JjPSJodHRwczovL2ltZy5hbGljZG4uY29tL2ltZ2V4dHJhL2k0LzIyMTEyNDAyMjgwNzEvTzFDTjAxbWo3dUxzMjlVWlFGVW91Tm9fISEyMjExMjQwMjI4MDcxLmpwZyI+PGltZyBzcmM9Imh0dHBzOi8vaW1nLmFsaWNkbi5jb20vaW1nZXh0cmEvaTEvMjIxMTI0MDIyODA3MS9PMUNOMDFIazhCRVgyOVVaUHlyZkNMdl8hITIyMTEyNDAyMjgwNzEuanBnIj48aW1nIHNyYz0iaHR0cHM6Ly9pbWcuYWxpY2RuLmNvbS9pbWdleHRyYS9pNC8yMjExMjQwMjI4MDcxL08xQ04wMXdndW5zSDI5VVpRRWo1RGlLXyEhMjIxMTI0MDIyODA3MS5qcGciPjxpbWcgc3JjPSJodHRwczovL2ltZy5hbGljZG4uY29tL2ltZ2V4dHJhL2kzLzIyMTEyNDAyMjgwNzEvTzFDTjAxOFo5c0xyMjlVWlFEYWY4N2ZfISEyMjExMjQwMjI4MDcxLmpwZyI+PGltZyBzcmM9Imh0dHBzOi8vaW1nLmFsaWNkbi5jb20vaW1nZXh0cmEvaTQvMjIxMTI0MDIyODA3MS9PMUNOMDFkYXZTYVEyOVVaUThGYTYzUV8hITIyMTEyNDAyMjgwNzEuanBnIj48aW1nIHNyYz0iaHR0cHM6Ly9pbWcuYWxpY2RuLmNvbS9pbWdleHRyYS9pMy8yMjExMjQwMjI4MDcxL08xQ04wMUJOREJieDI5VVpRM2k4TnFjXyEhMjIxMTI0MDIyODA3MS5qcGciPjxpbWcgc3JjPSJodHRwczovL2ltZy5hbGljZG4uY29tL2ltZ2V4dHJhL2kyLzIyMTEyNDAyMjgwNzEvTzFDTjAxR0tVVmRzMjlVWlFBNEVReVRfISEyMjExMjQwMjI4MDcxLmpwZyI+PGltZyBzcmM9Imh0dHBzOi8vaW1nLmFsaWNkbi5jb20vaW1nZXh0cmEvaTMvMjIxMTI0MDIyODA3MS9PMUNOMDEyZFdleEUyOVVaUTkyTU5Fcl8hITIyMTEyNDAyMjgwNzEuanBnIj48aW1nIHNyYz0iaHR0cHM6Ly9pbWcuYWxpY2RuLmNvbS9pbWdleHRyYS9pNC8yMjExMjQwMjI4MDcxL08xQ04wMWtLZ2ZpaDI5VVpQeXJmVDEyXyEhMjIxMTI0MDIyODA3MS5qcGciPjxpbWcgc3JjPSJodHRwczovL2ltZy5hbGljZG4uY29tL2ltZ2V4dHJhL2k0LzIyMTEyNDAyMjgwNzEvTzFDTjAxUm5Jd3J5MjlVWlE4THRoSkRfISEyMjExMjQwMjI4MDcxLmpwZyI+PGltZyBzcmM9Imh0dHBzOi8vd3d3Lm8wYi5jbi9pLnBocD90LnBuZyZyaWQ9Z3ctNC42N2Y0M2ZmOTA3YWE4JnA9MTQ4OTM3NjYzMyZrPWUuY29tJnQ9MTc0NDA2MDQxMSIgc3R5bGU9ImRpc3BsYXk6bm9uZSI+
Продавец:芭沁瑾旗舰店
Рейтинг:

Всего отзывов:0
Положительных:0
Выберите вариацию / цвет
Добавить в корзину
- Информация о товаре
- Фотографии
| Цвет: | 5 комбинаций цвета кофе (овощная лопата+ложка+Коландер+жареная лопата+кронштейна), 6 комбинаций цвета кофе (овощная лопата+ложка+Коландер+жаркая лопата+рисовая ложка+кронштейн), 7 Комбинации цвета кофе (овощная лопата+ложка+Коландер+жареная лопата+розовый стейк+ложка риса+кронштейн), Комбинация Yasibai 5 (овощная лопата+ложка+Корандея+жаркая лопата+кронштейна), Комбинация Yashi Bai 6 (овощная лопата+ложка+Корандея+Фрирование+Рисовая ложка+кронштейн), Комбинация Yashi Bai 7 (овощная лопата+ложка+Корандея+жаркая лопата+розовый стейк+ложка риса+кронштейн) |